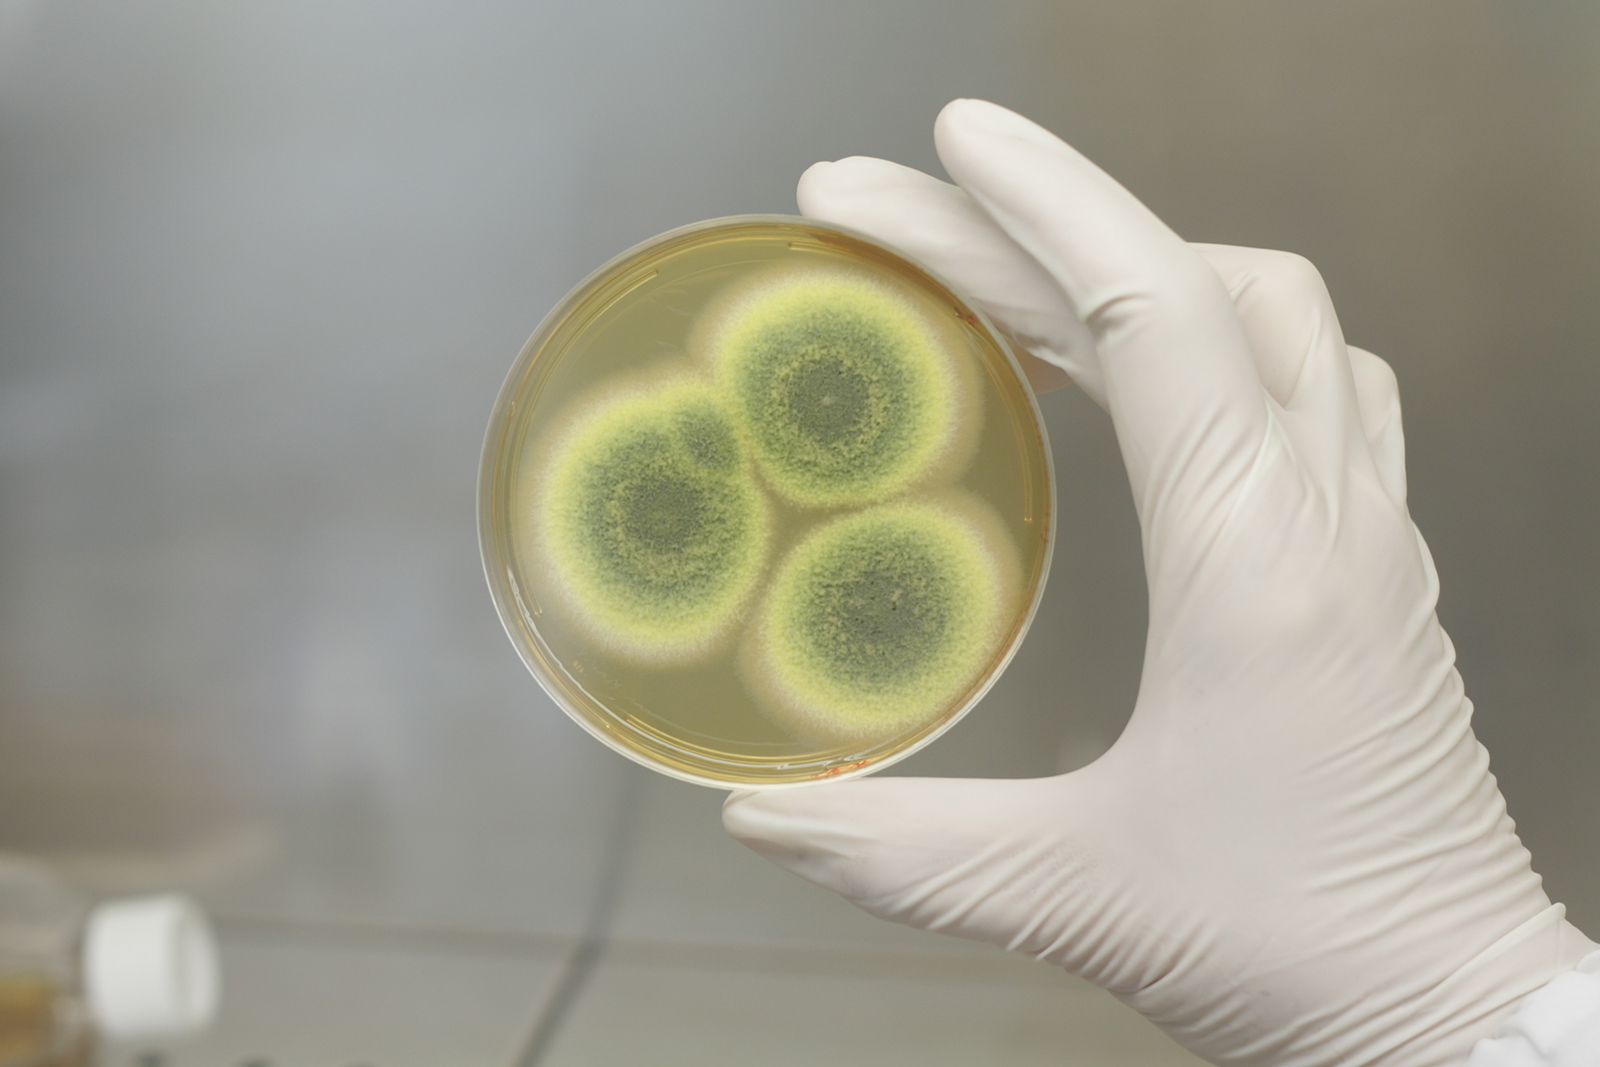
Gallery image 3 — home mold inspection Miami-Dade County FL

When you suspect mold in your Miami-Dade County FL home or business, you need a partner you can trust. CSI Mold Specialist is that partner. For over 15 years, our team of Florida-licensed Mold Assessment Consultants has been the leading choice for comprehensive mold inspection, testing, and remediation services across Miami-Dade County FL.
Our mission is simple: to keep your indoor environment safe and healthy. We understand the stress and health risks that come with mold exposure, which is why we treat every property with the utmost care and precision. We are fully licensed and insured, providing you with unbiased, professional assessments you can rely on.
What sets us apart is our commitment to a thorough process. We don't just look for visible mold; we use advanced technology like infrared thermography and laser scanners to find hidden moisture sources and potential problems behind your walls. Our detailed inspection reports give you a clear, actionable understanding of your situation.
You deserve a mold specialist who listens to your concerns, respects your property, and provides transparent, effective solutions. At CSI Mold Specialist, your safety is our number one priority. Let our experienced team give you the peace of mind that comes with a mold-free property.